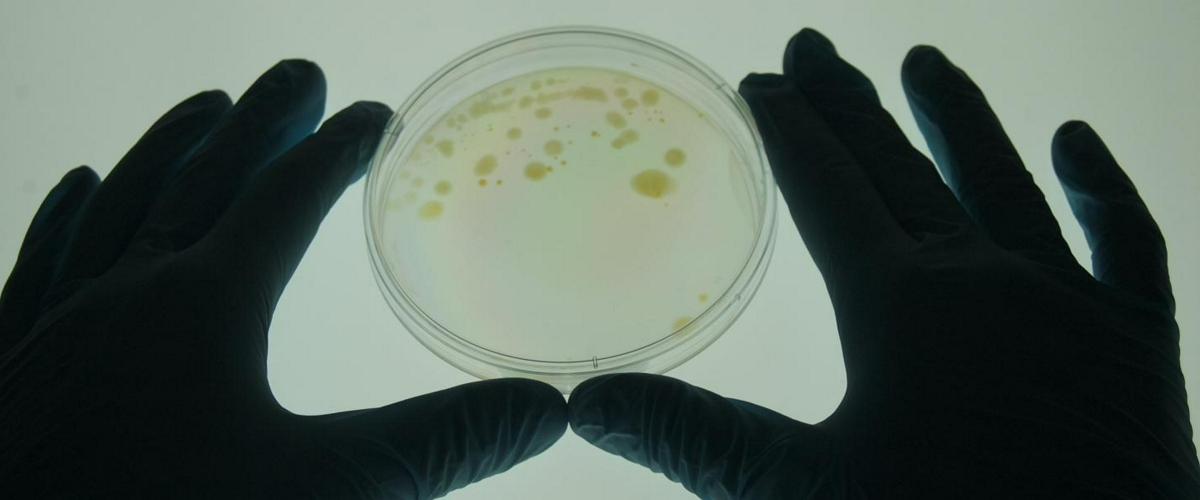
TODO:

Хотя современная медицина позволяет предотвращать и эффективно лечить туберкулез, эта болезнь все еще уносит миллионы жизней. Масштабная вакцинация могла бы улучшить положение, однако существующая вакцина БЦЖ несовершенна и плохо защищает взрослых людей, особенно носителей закрытой формы болезни.
Специалисты, о работе которых рассказывает New Atlas, представили результаты второй фазы клинических испытаний новой вакцины против туберкулеза. Они проводились в странах Африки южнее Сахары в течение нескольких лет. В двойном слепом плацебо-контролируемом исследовании приняли участие 3500 человек в возрасте старше трех лет.
Исследование выявило 26 новых случаев активного туберкулеза в группе, получившей плацебо, и 13 — в группе, получившей вакцину. Таким образом, ее эффективность составляет 50%.
Новая вакцина не обеспечивает полную защиту от болезни. Тем не менее, даже такая «половинная» эффективность позволит спасти множество жизней. Еще важнее, что препарат впервые смог защитить от туберкулеза взрослых людей с закрытой формой заболевания. Побочных эффектов у вакцины выявлено не было.
Третья фаза испытаний должна подтвердить полученные результаты на более широкой выборке. В случае успеха авторы рассчитывают ввести вакцину в клиническую практику в течение 7-10 лет.
Австралийские ученые представили свою разработку — вакцину-спрей, которая защищает от туберкулеза в любом возрасте. Она основана на двух пептидах, выделенных из бактерий.